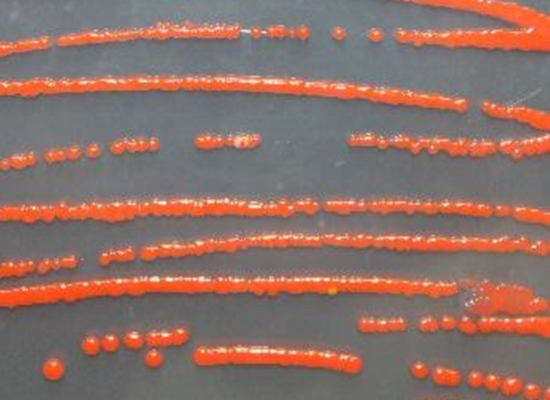
redish dots of liquid in a low/ line

Innovation in the oil industry - questioning the status quo
Vienna Textile Lab was conceived at an international innovation competition (ClimateLaunchpad 2017). Karin Fleck (Founder & CEO), who was working as a start-up consultant at the time, entered the competition to understand the founding process of start-ups and gain a better understanding of the needs of a young company and the obstacles it faces. The idea of creating dyes with microorganisms came from a friend, who was teaching this topic and underlining the lack of research in this area. As an analytical and physical chemist with an interest in dyes, Karin took it upon herself to try and see whether this idea had market value and how to bring it into life by practical application. The response in the competition was positive, Vienna Textile Lab won the 3rd place and the Audience award and Karin kept working on the idea since, eventually founding a start-up herself. The desire for change or innovation had been forming in Karin´s mind for a while, even before entering the competition. She studied technical chemistry to gain a great understanding of what materials are made of. Before her consultant job, Karin had a successful career in the corporate world of the oil and gas industry, working in management positions in energy trading. This gave Karin a deep insight into where resources come from. The complex and result driven environment of trading was a great preparation for startup life.
It became more obvious and important to her to show alternatives to fossil-based materials, and to change people's attitudes towards their production. The inspiration for the topic came and was supported by the courses on “bacterial dyes and textiles”, offered by the Textile Lab Amsterdam. This low-level threshold access to technology and innovation enabled interested and proactive people like Karin to develop and test an idea in the real world.
In 2021 Vienna Textile Lab was registered as a GmbH. Until then, the young company has faced many challenges. For once, the timing for founding a start-up was rather unfortunate: with the start of the COVID pandemic. Also, finding a suitable and affordable lab space for small companies proved to be a struggle. Another issue was to find senior talent
“Somebody needs to be visionary about this”
, states Karin. In the end, she assembled an interdisciplinary team. Karin´s team consists of bioengineers, chemists, as well as industrial designers. Karin herself also has experience in process development, optimisation and strategy. As Austria did not have a textile lab at the time and Karin was part of a European lab collaboration called “Textile, Clothing and Business Labs”, Karin decided to choose a similar name and give Austria – or more specifically Vienna - it´s first textile lab.
Rethinking the resources and materials to preserve our planet
Vienna Textile Lab develops and manufactures dyes and pigments by utilizing microorganisms. The latter produce pigments
“not because they feel so funky and they want to dress funny”
, jokes Karin, but as a secondary metabolite in response to stress. The start-up focuses on bacteria and fungi derived from the soil or of marine origin. Dyes and pigments fall under the category of fine chemicals and are at the end of a chemical supply chain. In the oil industry, the process starts with crude oil, which needs to be processed to bulk chemicals and many steps later the fine chemicals are obtained. High emission and a heavy carbon footprint are a negative side effect. With their biotechnological approach, VTL´s pigments are produced in a cell, therefore eliminating many single complex steps of the manufacturing process. Not only does this reduce the carbon footprint of the process significantly, but the used renewable feedstock contributes to a circular -economy. It´s a one-pot reaction, which is followed up by purification.
“Our goal is to successfully combine sustainability, safety, and performance to generate a commercially viable alternative to traditional synthetic dyes and pigments”
, states Karin. Next steps for Vienna Textile Lab
Currently, Vienna Textile Lab cooperates with a Spanish start-up (Care Applications), which specializes in a highly efficient dyeing method that reduces the water use drastically. VTL is proud member of the New European Bauhaus Catalyse Programme (EIT) and supported by Austrian and European peer reviewed funding schemes. Furthermore, VTL works closely with customers, such as fashion brands and textile mills. The plan for the near future is to finalise the current investment round. Last but not least, the start-up focuses on further scaling their product and increasing revenue from pigment sales.
With their innovative approach, Vienna Textile Lab actively contributes to SDG 12 (responsible consumption and production), SDG 13 (climate action), SDG 14 (life below water) and SDG 15 (life on land).